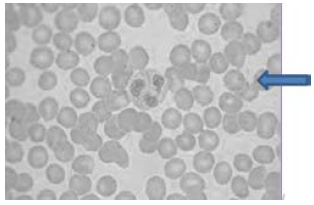
Enunciado 573972-1

Foram encontradas 40 questões.
Provas
Provas
Provas
Analise o texto a seguir, referente à transmissão do Trypanosoma cruzi.
O inquérito sorológico nacional, realizado no final da década de 70, estimou a existência de 5 milhões de brasileiros infectados pelo Trypanosoma cruzi. Grande parte dessas infecções se deram na área rural, em virtude do contato dos indivíduos com fezes de triatomíneos domiciliados. Até recentemente, esta era a principal forma de transmissão da infecção. As medidas de controle adotadas, centradas no combate dos vetores domiciliados com inseticidas, proporcionou a virtual eliminação da principal espécie vetora no país, o Triatoma infestans.
Diponível em: <http://www.cpqrr.fiocruz.br/informacao_em_ saude/CICT/Doenca_de_chagas.htm>. Acesso em: 20 nov. 2015.
Com base nas informações do texto e considerando essa temática, é CORRETO afirmar que a eliminação do Triatoma infestans dos domicilios:Provas
Num total de 19.463 exames de fezes, realizados de 19 de janeiro de1972 a 31 de dezembro de 1977 no Hospital Santa Maria Bertila de Guiratinga (Mato Grosso), 270 apresentaram ovos vivos de Schistosoma mansoni. Com referência à naturalidade, 229 pacientes eram naturais do estado de Minas Gerais, 17 de Pernambuco, 14 da Bahia, quatro de Alagoas, três do Piauí e três de Mato Grosso. Dos três pacientes de Mato Grosso, dois são naturais e residem no município do Rio Negro e um reside no município de Rondonópolis, sendo natural de Poxoréo. Os três nunca saíram do estado. É a primeira constatação de esquistossomose mansoni autóctone no estado do Mato Grosso.
Com base nas informações do texto e considerando essa temática, é CORRETO afirmar:
Provas
Analise a imagem a seguir, que apresenta um tipo de alteração leucocitária.

Após análise da imagem, é CORRETO afirmar que a alteração visualizada é causada por:
Provas
A imagem a seguir, apresenta células sanguíneas.
Provas
A charge a seguir faz menção a três importantes doenças brasileiras.

É CORRETO afirmar que as três doenças citadas na charge têm em comum a transmissão do agente patogênico pela mesma:
Provas
Observe a imagem a seguir.

Após análise da imagem, é CORRETO afirmar que as formas evolutivas pertencem ao parasito:
Provas
Analise as imagens a seguir, que simulam uma tipagem sanguínea.

Após a análise das imagens, é CORRETO afirmar que o tipo sanguineo é:
Provas
Caderno Container